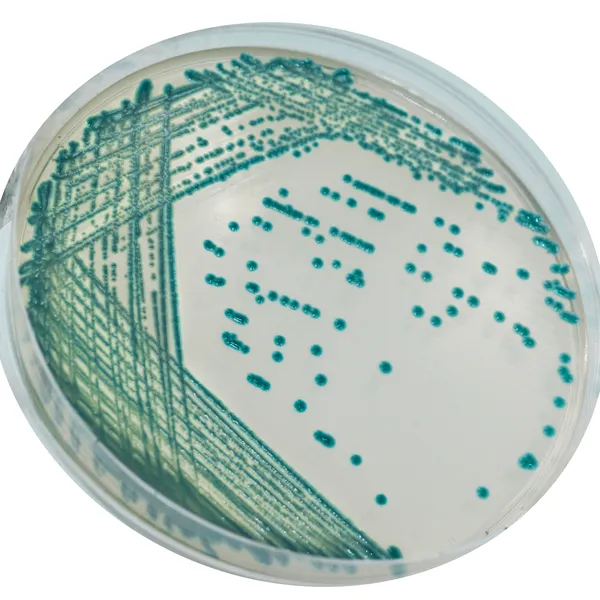
CHROMagar™ Serratia

Colonies Appearance

S. marcescens
Green-blue to metallic blue
Performance
Performance
Serratia species are implicated in nosocomial infections. In several countries, Serratia marcescens is frequently associated with epidemics in intensive care units and in particular in neonatal and pediatric units. Surveillance of nosocomial infections requires effective recovery of clinical isolates from faeces, wound exudates and respiratory samples to prevent problems of cross infection and potentially fatal infections. In this context, CHROMagar™ has developed CHROMagar™ Serratia, a culture medium perfectly suited to the search for S. marcescens in faeces.
In addition, S. marcescens is able to survive days to months on surfaces, distilled water and hand soap, making it an important pathogen in nosocomial infections and sporadic epidemics.
Intended Use :
CHROMagar™ Serratia is a selective and differential chromogenic culture medium, intended for use in the qualitative direct detection of colonization with Serratia marcescens to aid in the prevention and control of Serratia marcescens in intensive care unit (ICU), notably neo-natal. The test is performed with rectal swabs, throat swabs, wound swabs and stools from patients to screen for Serratia colonization. It can also be used in hygiene monitoring in the clinical environment with surface sampling. Results can be interpreted after 18-24 h of aerobic incubation at 35-37 °C.
CHROMagar™ Serratia is not intended to diagnose Serratia infection nor to guide nor monitor treatment for infections. A lack of growth or the absence of colonies on CHROMagar™ Serratia does not preclude the presence of Serratia. Further identification, susceptibility testing, and epidemiological typing is needed on suspect colonies.
3. High specificity and lower workload : The conventional media used for the detection of S. marcescens like MacConkey Agar has very poor specificity, creating an abundance of false positives. Because all lactose negative bacteria have a similar aspect than S. marcescens.
On the contrary, CHROMagar™ Serratia detect all Serratia (those pigmented or not) and allows technicians to focus on the real contaminated samples.
4. Intense green-blue colouration for easy reading compared to conventional media (MacConkey, Blood Agar).
5. Fast results particularly useful in case of sudden outbreak of Serratia marcescens.
Composition

Technical Documents
Scientific Publications
2021
Evaluation of CHROMagar Serratia agar, a new chromogenic medium for the detection and isolation of Serratia marcescens
📄 Publication2020
Validation of Colorex™ (CHROMagar™) Serratia agar on WASP™/WASPLab™ in screening for Serratia marcescens in neonatal intensive care units using the ESwab™
📄 Publication

Read more